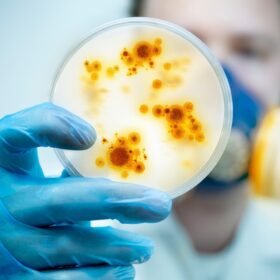

Užsienio žurnalistų prognozės: kas laimės „Eurovizijos“ LT finalą 2026?
Artėjant Lietuvos nacionalinės „Eurovizijos“ atrankos kulminacijai, intriga pasiekė aukščiausią tašką ne tik šalies viduje, bet ir tarptautinėje arenoje. Užsienio muzikos žurnalistai ir didžiausių „Eurovizijos“ tinklaraščių autoriai šiemet kaip niekad atidžiai stebi lietuvių pasirinkimus. Jų nuomone, Lietuva pagaliau perprato konkurso formulę ir į finalą delegavo kūrinius, kurie išsiskiria ne tik kokybe, bet ir modernumu. Kai kurie kritikai drąsiai rėžia: šiemet mūsų atrankoje dalyvauja atlikėjas, kuris ateityje gali parvežti stiklinį mikrofoną į Vilnių.
Vieningas balsas: Lietuva – „juodasis arkliukas“
Tarptautiniai ekspertai pastebi, kad Lietuvos atrankos lygis per pastaruosius kelerius metus stipriai išaugo. Užsienio apžvalgininkai pabrėžia, kad mūsų finalininkai nebesistengia kopijuoti praėjusių metų laimėtojų, o kuria autentišką, dažnai drąsų ir net rizikingą turinį. Pasak žurnalistų, viena iš dainų turi „nugalėtojos DNR“ – tai retas derinys tarp stipraus vokalo, įsimintinos melodijos ir vizualinio išpildymo, kuris būtų suprantamas bet kuriam Europos gyventojui, nepriklausomai nuo kalbos barjero.
Kritikų numylėtiniai ir didžioji intriga
Nors oficialūs balsavimo rezultatai paaiškės tik finalo vakarą, užsienio forumuose ir muzikos platformose jau ryškėja favoritai. Kritikai žavisi Lietuvos gebėjimu derinti alternatyviąją muziką su populiariaisiais ritmais. Vienas iš atlikėjų sulaukė ypatingo dėmesio dėl savo charizmos ir sceninės energijos, kurią ekspertai lygina su didžiausiomis pasaulio žvaigždėmis. Teigiama, kad šis pasirodymas didžiojoje scenoje sukeltų tikrą sensaciją ir leistų Lietuvai kovoti dėl aukščiausių vietų dešimtuke ar net pirmojo trejeto.
Kodėl prognozės tokios palankios būtent dabar?
Muzikos žurnalistai aiškina, kad „Eurovizijos“ kontekstas keičiasi – žiūrovai vis labiau vertina nuoširdumą ir profesionalumą, o ne pigius triukus.
Lietuva, panašu, pataikė į šią bangą. Be to, sėkmingas praėjusių metų pasirodymas suformavo teigiamą šalies įvaizdį, todėl dabar į kiekvieną mūsų atstovą žiūrima per padidinamąjį stiklą. Ekspertai pataria lietuviams nebijoti pasirinkti to, kas atrodo „kitaip“, nes būtent unikalumas šiemet bus pagrindinis raktas į sėkmę didžiausiame Europos muzikos renginyje.Galiausiai, užsienio žurnalistų prognozės suteikia papildomo pasitikėjimo, tačiau galutinį sprendimą priims Lietuvos žiūrovai ir komisija. Svarbiausia, kad šiemet diskusijos sukasi ne apie tai, ar pavyks patekti į finalą, o apie tai, kaip aukštai galime pakilti. Tai rodo, kad mūsų muzikos industrija subrendo ir yra pasirengusi dideliems laimėjimams. Nesvarbu, kas laimės nacionalinį finalą, akivaizdu viena – Lietuva šiemet bus viena iš labiausiai aptariamų šalių „Eurovizijos“ užkulisiuose.

Redaktorius, atsakingas už turinio kokybę, aiškumą ir sklandų pateikimą. Jis rūpinasi, kad straipsniai būtų informatyvūs, tikslūs ir atitiktų aukščiausius kalbos bei redagavimo standartus.